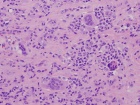
Zoom image: Cell stain

Case 11
K.T. - 28 year old female with intermittent left hip pain for several years; she began having more frequent and intense pain a few months ago, prompting her to seek treatment
Upcoming Events
Import medical school events to your Exchange, Gmail, iPhone or iPod calendar. Customize your calendar by selecting different event categories and receive automatic reminders of the school events that matter most to you.